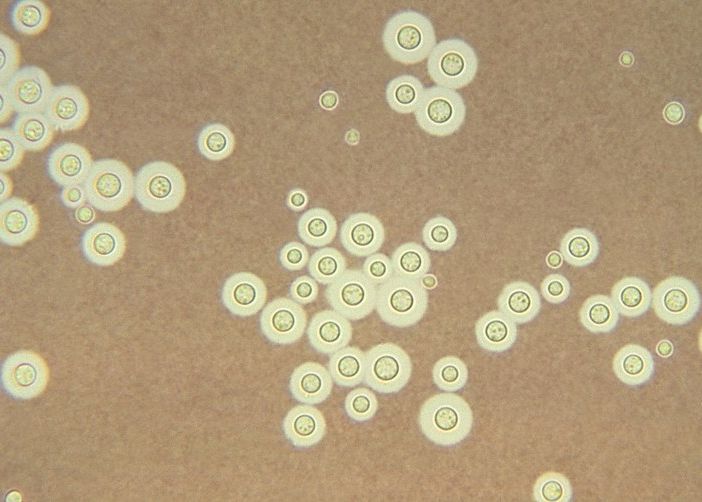
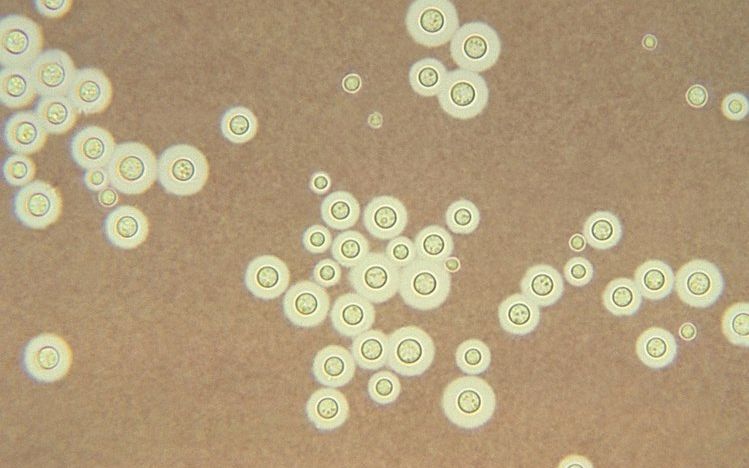
Descoperirea Incredibila Facuta De Cercetatori Pe Peretii Reactorului Nuclear 4 De La Cernobil

Descoperirea incredibilă făcută de cercetători pe pereții reactorului nuclear 4 de la Cernobîl
În împrejurimile apocaliptice ale centralei nucleare de la Cernobîl se întâmplă lucruri care i-au lăsat pe oamenii de știință cu gura căscată.
După ce au trimis în recunoaștere roboți care să exploreze zona, aceștia au descoperit că pe zidurile reactorului nuclear 4, care a fost decimat în timpul dezastrului ecologic, cresc ciuperci negre care se hrănesc cu grafitul rezultat în urma exploziei nucleului centralei. Mai mult, acestea par chiar să se extindă către zonele cu radioactivitate crescută, fiind atrase în mod special de această particularitate.
Cercetătorii au reușit chiar să recolteze probe ale acestor ciuperci și, după ce le-au analizat în laborator, au remarcat că, spre deosebire de alți fungi, ele chiar cresc mai rapid în prezența radiațiilor. Cele trei specii testate - Cladosporium sphaerospermum, Cryptococcus neoformans și Wangiella dermatitidis au în compoziție cantități mari de melanină, un compus care se găsește, printre altele, în structura pielii umane, oamenii cu o nuanță de piele mai închisă având o cantitate mult mai mare. Melanina absoarbe lumina și disipează razele ultraviolet, însă în structura ciupercilor se pare că absoarbe radiațiile și le transformă în energie chimică pe care o utilizează pentru creștere și dezvoltare, într-un mod similar în care plantele folosesc clorofila.

Pentru a afla și mai multe despre comportamentul ciudat al acestor ciuperci radioactive, oamenii de știință au recoltat opt specii pe care le-au trimis pentru teste specialiștilor de pe Stația Spațială Internațională, pentru a observa cum se comportă atunci când sunt expuse la o cantitate de radiații de până la 80 de ori mai mare decât pe Terra. Aceștia sperau că organisemele vor putea produce, mai departe, molecule care să fie adaptate în producția de medicamente ce ar putea fi administrate astronauților pentru a-I proteja de radiații în timpul misiunilor îndelungate. Rezultatele se lasă încă așteptate și ar putea fi unele spectaculoase.